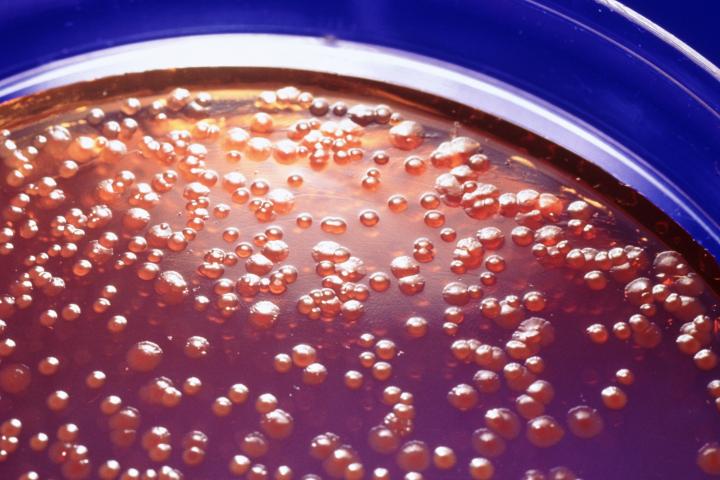
Imagen de archivo de un cultivo de laboratorio con salmonella.

Un brote de salmonelosis en Badajoz deja 25 afectados, de ellos cinco hospitalizados
Las manifestaciones clínicas comenzaron tras haber comido en un restaurante de la ciudad.
Un brote de salmonelosis originado en un restaurante de Badajoz ha afectado a 25 personas, de las que siete han precisado ingreso hospitalario y actualmente continúan ingresados cinco, según han informado a EFE desde el Servicio Extremeño de Salud (SES).
La Dirección General de Salud Pública ha confirmado este brote de origen alimentario en la capital pacense, tras comprobar el aislamiento de salmonella en las muestras de los pacientes.
Las manifestaciones clínicas comenzaron tras haber comido en un restaurante de la ciudad.
Ante estos hechos, se pusieron en marcha los protocolos establecidos de vigilancia epidemiológica y seguridad alimentaria previstos para estos casos y se continua con las actuaciones e investigaciones indicadas.
Asimismo, se ha procedido al cese temporal de actividad del establecimiento.










